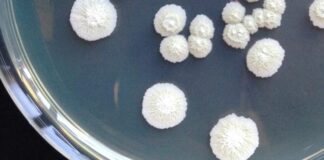
Crea, collezione microbica del vino nell’organizzazione Ue

28 Pastai, prima pasta di Gragnano con zero pesticidi e glifosato
ROMA (ITALPRESS) - 28 Pastai è la prima pasta di Gragnano IGP con zero pesticidi e glifosato. Prodotta nell'edificio storico che agli inizi del...
Inaugurato a Reggio Emilia il Cirfood District
REGGIO EMILIA (ITALPRESS) - Inaugurato oggi a Reggio Emilia il Cirfood District, il centro di ricerca e innovazione dove progettare e sperimentare nuove soluzioni...
Crea, collezione microbica del vino nell’organizzazione Ue
ROMA (ITALPRESS) - La collezione microbica del CREA Viticoltura ed Enologia CREA-CMVE (CREA-Collezione di Microorganismi di habitat Viticolo Enologico) è stata ammessa in ECCO...
Da Barilla a Voiello, Mondadori pubblica poster grandi aziende italiane
SEGRATE (MILANO) (ITALPRESS) - Dalla collaborazione con gli archivi storici delle più grandi aziende italiane nasce "Poster, le grandi aziende italiane", la speciale iniziativa...
Campagna #NoFakeFood a tutela del made in Italy
ROMA (ITALPRESS) - Secondo le ultime stime della Coldiretti, è salito da 100 a 120 miliardi il valore del falso Made in Italy agroalimentare...
Consorzio Parmigiano Reggiano al Sial di Parigi
REGGIO EMILIA (ITALPRESS) - Il Consorzio del Parmigiano Reggiano sarà protagonista al Sial, l'evento biennale b2b dedicato al food che si terrà a Parigi...
Al via progetto coordinato da Enea per la sicurezza alimentare
ROMA (ITALPRESS) - Rafforzare l'eccellenza scientifica italiana nella sicurezza alimentare attraverso lo sviluppo di piattaforme e servizi per la qualità, autenticità e rintracciabilità di...
L’eccellenza italiana torna al Sial di Parigi
ROMA (ITALPRESS) - Dopo due anni di stop, il Sial di Parigi torna con un'edizione all'insegna della sostenibilità alimentare. Un'attenzione particolare al tema...